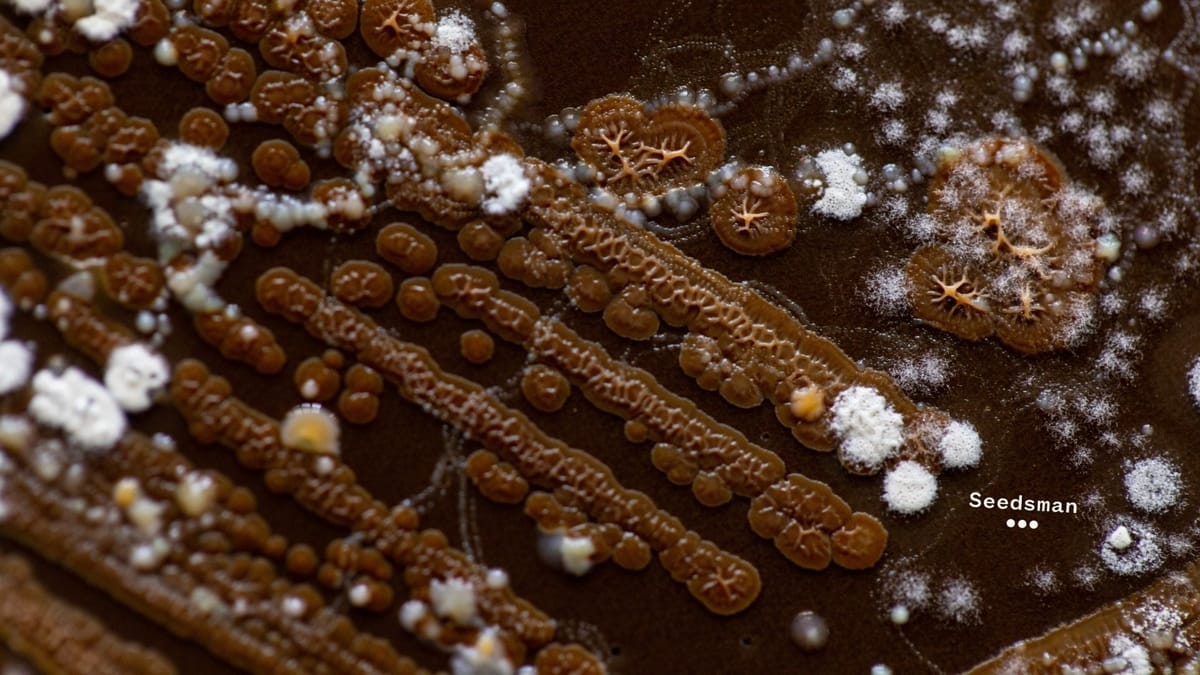

JADAM Microbial Solution (JMS for short) is a powerful solution for your soil. You may be wondering what it is, how it works, and what you use it for. If so, read on.
In this article, I will answer these questions and talk about how to make it. As you will learn, JMS is an amazing solution to add to your arsenal of homemade, natural amendments.
The Origins of JADAM
We’re going to first talk about Korean Natural Farming before talking about JMS. This is because JMS started its life with Korean Natural Farming (KNF for short) back in the 60s with Dr Cho Han Kyu. Dr Cho wanted to bring something to western farming that would prevent the leaching of the land. He helped revolutionise agriculture to become self-sustainable at minimal cost to the farmer.
As he started having a family, his son, Youngsang Cho, took over where his father left off, further fine-tuning KNF by adding JADAM. JADAM stands for Jayonul Damun Saramdul (the name of the organisation that was created by Mr Cho), which means “people who are like nature.” JADAM is more than just a microbial solution, though. It is a form of farming that runs in line with KNF.
The Principles of JADAM
Like KNF, JADAM is a way to provide a natural way of farming that almost eliminates cost. It’s a way to use simple principles that are easy to follow. Just like KNF, Mr Cho utilises the scientific method to prove that this way of treating the soil works better than any other fertiliser, revitalising the soil at deeper levels, and it is something that cannot be bought on a store shelf. You must use fresh materials that you find in the wild. You are basically bringing a copy of the forest floor to your own garden.
Bringing Microorganisms to Your Soil
In JADAM, there’s a way to bring a multitude of microorganisms to your own soil. The reason you want to do this is so you can loosen soil, prevent compaction, help retain water, and even keep non-beneficial organisms/microorganisms at bay. The reason this works is when you bring those organisms from the forest floor; where there’s an almost perfect cycle of life, death, decay, leading back to life, you are going to bring both the “good” and the “bad” microbes, to create a balance in that soil.
Notice I put quotes around 'good' and 'bad'. There’s a reason for that. In KNF and JADAM, we don’t see microorganisms as good or bad, more along the lines of balance. You must have some of the 'bad' to help feed the 'good' and help the plants and/or crops develop a healthy and strong immune system. You want a balance.
Why use JMS?
JMS can help you develop a healthy plot of soil that you can grow anything you want in, and that soil will maintain its health even after the harvest.
How to Make JMS
Making JMS is very simple. You’re only going to need a 5-gallon bucket with 4 gallons of water with no chlorine, chloramine, or fluoride. You will also need a stick to hang your potatoes and leaf mould from, one pound of white potatoes (you can technically use any, white is just cheaper where I am), sea salt (must be sea salt or the solution won’t work at all or be as potent) or seawater, two socks/pantyhose/cheesecloth bags, and, finally, leaf mould with soil.
That’s it, really. All you are going to do is walk out to the woods/forest/mountains and find a place where many leaves have fallen. When you do, start to sweep them away. Underneath, you should see something that looks almost like extremely dark soil. That’s leaf mould.

Grab that and about an inch of the soil underneath it. You may also come across some other microbes that look like spiderwebbing running through the soil. Use it. Pictures are shown below as well:


Once you have your leaf mould, soil, and microbes, bake your potatoes until they are soft and easy to squish. Once that is done and they have cooled off, grab all the other materials; it’s time to get the process going. Just follow the steps as you go.
Steps for Making JMS
1. Take the sea salt and add roughly 15 grams (measurements do not need to be exact) to the bucket of water. If you are using seawater, I add an extra ounce.
2. Take your potatoes, add them to one of the bags/socks/pantyhose, and hang it from the stick into the water.
3. Take your soil, add it to the other bag, and hang it next to the potatoes.
4. Massage the bag containing the leaf mould and soil with microbes until you start seeing the water turn dark.
5. Massage the potatoes, ensuring you smash them in the process. You may start to see foam appear. That’s an excellent sign.
6. Cover the bucket with a plastic bag or loose, light cloth, and place it somewhere that matches the temperature of your soil and grow area. This ensures you get the microbes for that temperature range.
7. Let it sit for 2-5 days. This is dependent on the weather. Warmer weather makes the process happen faster.
When it is finished brewing, you should see a good amount of foaming. This is officially at its peak. Now, you want to use the solution right away. You mix this as a ratio of 1:20. So, going by ounces, it would be one ounce for every 20 ounces of water (I do the same with millilitres) and watering the soil around your plants. If you used this as a foliar spray, you would mix it at a 1:100 ratio. Pictures are shown below:



As you can see, over two days, you see foam floating at the top. You may have a funky smell to it. That’s perfectly fine. These microbes are going to help your soil life. It’s adding bacteria (more than what has been discovered so far by man), nematodes, and other forms of micro life that make your soil a living soil. You’re going to want to dilute this at a 1:20 ratio again. Then, just water your plants with it.
Increasing Soil Health
JMS is going to add microbes from the forest to your soil. It will increase soil health by making your soil a living soil. If you have issues with compaction or clay, this will help break it up and make its loam. If you have sandy soil that drains fast, adding this with a small amount of soil will make it sandy loam.
Happy Plants
Your plants are going to love it. Though it may seem dirty to us, it’s like a bath for its roots to a plant. If you love to grow in soil, give this a try. You never know. It could be the thing your farm or garden is looking for.